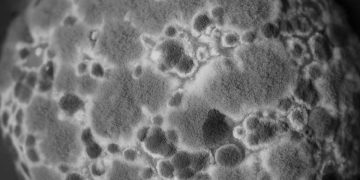
Bazı Zehirlenmeler ve Tedavileri

Antihistaminikler, Histamin canlılarda özellikle deri, solunum ve sindirim sistemi mukozası gibi dışarıya açılan dokularda yüksek düzeylerde bulunur. Antijenler, hayvansal zehirler,...
Read moreDetailsVetRehberi, Veteriner Hekimlik mesleği, hayvan sağlığı, hayvan hastalıkları, hayvan beslenmesi, hayvan ırkları, ebooks, sözlük, veteriner ilaçlar, yaban hayatı hakkında içerik yayınlayan ve soru-cevap ile hayvanlarınızın sorunlarına cevap veren bilgi platformudur.